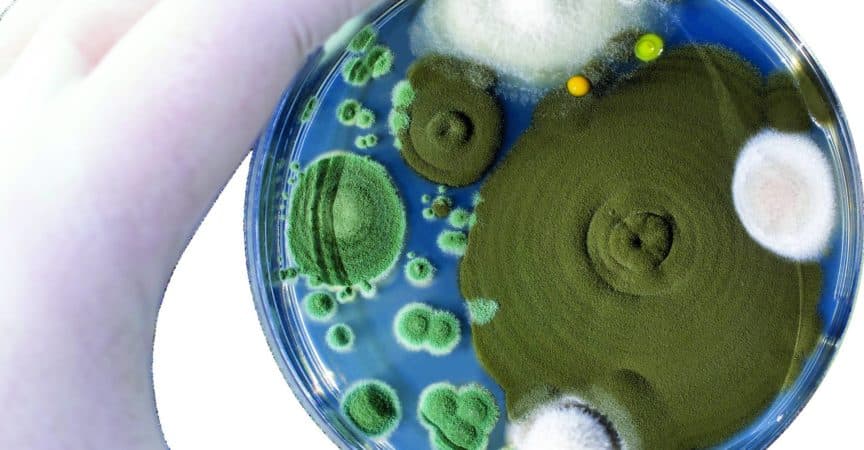

Schimmelpilzbelastung zwischen Allergie und Phobie
iStock/Dr_Microbe
Optisch durchaus ansprechend: Kolonien verschiedener Schimmelpilze aus der Luft.
Schimmelbestandteile kommen fast ubiquitär vor. Dennoch gibt es nur wenige Menschen, die wirklich gegen Pilze in der Schlafzimmerecke sensibilisiert sind. Drinnen sind es eher Toxine und Ko-Allergene, die den Betroffenen den Atem rauben. Draussen sieht es allerdings deutlich anders aus.